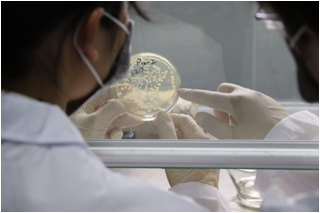
COD廢水處理

可生化降解COD:指的是在生化厭氧階段能被厭氧菌消耗的有機物。廢水中的有機物可分為易降解COD�����、難降解COD/不可能降解COD。易降解COD可迅速被活性污泥降解���。在廢水中可降解COD占比也稱生物可降解性。

可酸化COD:COD中被水解菌和酸化菌利用的底物��,在未酸化的廢水中�,并非全部CODBD可被甲烷菌利用�。CODBD首先被發酵菌轉化為細胞物質�����、氫氣和大量揮發性脂肪酸(VFA)����,其中轉化為細胞物質的COD(可記作CODcells)不再能被甲烷菌利用,其余部分才是可資甲烷菌利用的底物COD。這類COD就被稱為可酸化COD��。
生物抗性COD:廢水中不能被活性污泥用于發酵的有機化合物��。包括不能降解的“惰性有機物”和來不及進行活性污泥馴化的未降解有機物���。
可溶解性COD:一般把能通過膜的COD稱為真正溶解性COD��。能通過普通濾紙或離心法的不溶性有機物稱為膠體物質�����。
水解COD:能夠在厭氧階段被水解的聚合物COD稱為可水解COD。在過程中的某一階段以非聚合物形式存在的COD被稱為已水解COD。
在廢水中處理COD常見的方法主要有化學藥劑處理法及微生物菌劑降解法,此外���,芬頓����、電化學法也會在難降解有機物廢水處理中應用����。
相關內容:什么樣的COD去除劑才不違法